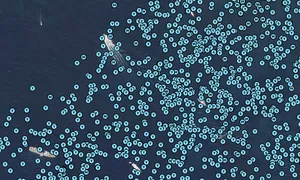

SERENITY, MMSI: 319267900
 Cayman Islands
Cayman Islands
Follow the journey
Images of SERENITY
Journey statistics
Preferred harbour type
2026
82% marina
natural harbour 18%
2025
58% marina
natural harbour 42%
2024
47% marina
natural harbour 53%
2023
73% marina
natural harbour 27%